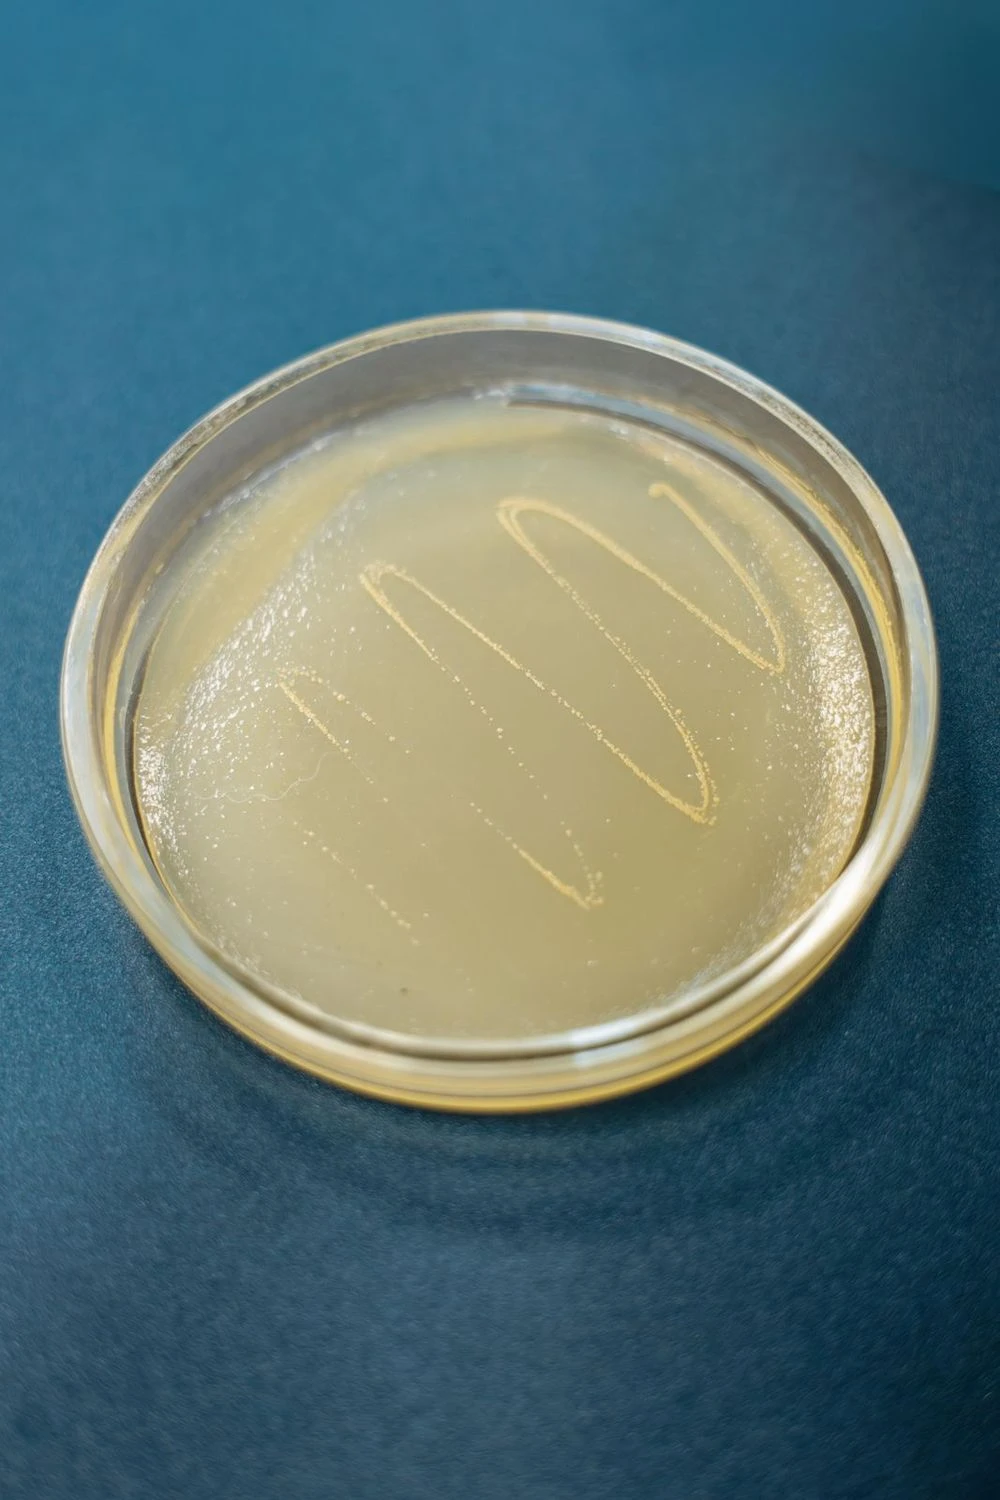

Каждый год через биологические очистные сооружения «Нижнекамскнефтехима» проходит около 50 миллионов кубометров сточных вод — объём, сопоставимый с целой рекой.
Это не только производственные, но и городские стоки. Прежде чем вернуться в Каму, вода проходит многоступенчатую очистку. Самый ответственный этап — биология. Здесь за результат отвечают не фильтры и реагенты, а живые микроорганизмы.
В самом центре этой системы — группа исследований биологической очистки сточных вод. Пять специалистов, которые подбирают, выращивают и «обучают» микробные сообщества для очистных сооружений по всей географии СИБУРа. Универсальных решений здесь не существует: под каждый завод, каждый тип стоков и каждый регион собирается свой «коктейль» полезных бактерий.

Как устроены современные очистные
Очистка начинается с механического и физико-химического этапов. Решётки, песколовки и отстойники удаляют крупные и взвешенные примеси. Затем городские и промышленные стоки смешиваются и поступают на биологическую очистку.
Именно здесь происходит главное: живые микроорганизмы разлагают органические соединения до воды и углекислого газа. После биологии вода проходит вторичные отстойники и обеззараживание — и только затем возвращается в Каму.
Чтобы в реку уходила только чистая вода
У биологической очистки есть и свои ограничения. Бактерии получают энергию, разлагая органические соединения. Но, например, ионы тяжёлых металлов — тот же хром — они расщепить не могут. Поэтому биологию невозможно полностью заменить фильтрами — и наоборот. Это всегда система, где методы дополняют друг друга.
Сергей Шилин — кандидат биологических наук, в микробиологии с 2001 года. Его зона ответственности — организация работы той самой группы исследований биологической очистки сточных вод:

Активный ил находится в аэротенках — больших резервуарах, заполненных бурой массой. Это и есть живые бактерии, которые перерабатывают загрязнения.

На «Нижнекамскнефтехиме» работают 12 аэротенков и 6 вторичных отстойников.
У биомассы «всё на лице написано»
Размер самих бактерий — около одного микрона. А для оценки агрессивности стоков используют и более крупных «помощников» — инфузорий-туфелек. Их выращивают и консервируют «для себя» специально как тест-объект.
Всего специалисты анализируют 15-20 параметров, включая химическое потребление кислорода, фенолы, аммоний, нитраты.
«Коктейль» для СИБУР-Кстово
Анастасия Сёмочкина работает в лаборатории и занимается выращиванием полезных микроорганизмов. В профессии она пять лет, окончила КНИТУ по направлению «биотехнология», магистратуру — там же. В Нижнекамск приехала осознанно — знала, что здесь работают уникальные биологические очистные сооружения.
Она объясняет: на БОС не существует «одной волшебной бактерии».
Таких запросов от производств в течение года обрабатывается немало, ведь группа закрывает нужды всего СИБУРа: ни в одной географии больше таких специалистов нет. Работа над каждым новым проектом начинается с запроса. Если на каком-то заводе появляются сложные стоки, специалисты получают образцы воды и активного ила. На их основе готовят твёрдую питательную среду — «корм», в котором выживают только нужные бактерии.
После серии пересевов получают чистую культуру. Затем её масштабируют: сначала в лаборатории, потом в биореакторе — большой «колбе», где автоматически поддерживаются параметры завода-заказчика: температура, подача воздуха, перемешивание. Там бактерии «тренируются» работать с нужными стоками.
Когда объём достаточен, живую культуру фасуют в канистры и отправляют на промышленную площадку — для опытно-промышленных испытаний.
Стартовая культура спокойно переносит транспортировку — бактерии умеют впадать в анабиоз при неблагоприятных условиях. Но работать они начинают только тогда, когда попадают в «родную» среду.
Объёмы тоже зависят от задачи. Самый крупный проект, который вспоминает Анастасия, — до 12-15 канистр живой культуры за один запуск. Этот «коктейль», способный работать с агрессивными щелочными и сульфидными стоками, специалисты группы «смешали» для СИБУР-Кстово.
Бактерии-терминаторы
«Раньше такие воды приходилось утилизировать за большие деньги и при помощи контрагента, — комментирует причины появления этого „коктейля“ Сергей Шилин. — Мы вывели бактерии, которые выживают при pH около 12, настоящие терминаторы. Это строго алкалофильные штаммы. Они очищают агрессивные стоки до уровня, при котором их можно безопасно направлять в общий коллектор».
Другой кейс команды — импортозамещение. На очистных «ЗапСибНефтехима» использовались иностранные бактерии с иностранной же биодобавкой для кормления, без которой, по утверждению поставщиков, система «умрёт». После 2022 года поставки прекратились. Перед бактериями встала угроза голодной смерти.
Часть разработанных группой штаммов уже запатентована и хранится во Всероссийской коллекции промышленных микроорганизмов — это официальная собственность компании.

Где раки зимуют
Несколько лет назад на выходе из вторичных отстойников (там, где вода после биологии готовится вернуться в реку) сотрудники очистных установили садок с раками. Раки не просто выжили — они чувствовали себя прекрасно.
Это говорит о том, что вода после биологической очистки действительно безопасна. Недаром раков используют в экологическом биомониторинге — они живут только в чистой воде.
Справка
Биологические очистные сооружения «Нижнекамскнефтехима» очищают 20% городских и 80% промышленных сточных вод Нижнекамска. Производство основано в 1978 году. В его реконструкцию, которая сейчас завершается, СИБУР инвестировал около 7 млрд рублей. Проект включает строительство новых зданий, модернизацию узла доочистки и обеззараживания, переход от хлорирования к ультрафиолету, использование тканевых дисковых фильтров и полную автоматизацию.
Алина Латыпова
MAX
